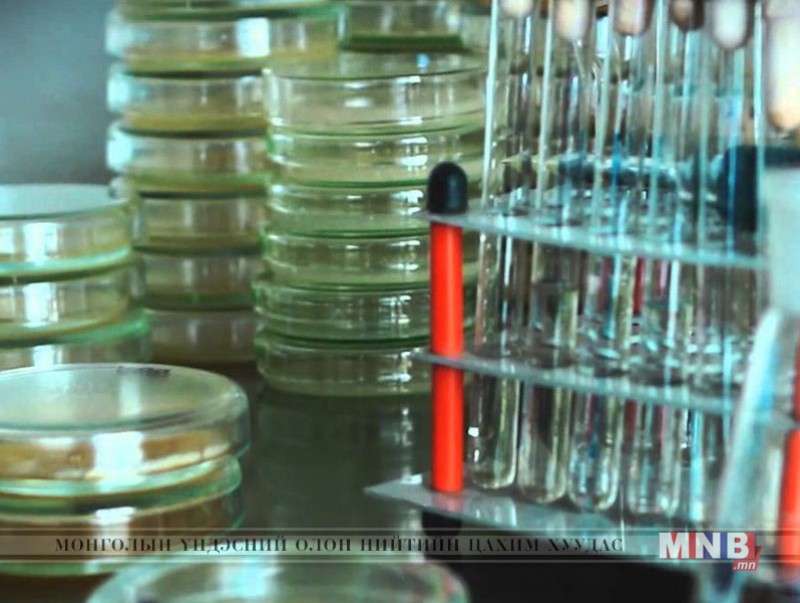

Дэлхий нийтээр эрүүл мэндийн шинжлэх ухаанд антибиотикоос татгалзах чиг хандлагатай байгаа. Мал эмнэлэгийн салбарт ч мөн адил антибиотикийн гаралтай малын эм, бэлдмэлээс зайлсхийж эхэлсэн. Тэгвэл үүнийг орлох үйлчилгээтэй байгалийн гаралтай бүтээгдэхүүнийг монгол эрдэмтэд хийж байна. Дэлгэрэнгүй мэдээллийг хүлээн авна уу.
| Монгол эрдэмтэд байгалийн гаралтай эм, бэлдмэл үйлдвэрлэж байна | ||
| Үзсэн: 1215 | Mongolian National Broadcaster |


 Үндэсний телевиз
Үндэсний телевиз



























































































































 Лханаагийн Мөнхтөр
Лханаагийн Мөнхтөр

 Р.Слава
Р.Слава

 Б.Цоожчулуунцэцэг
Б.Цоожчулуунцэцэг





Сэтгэгдэл бичих:
АНХААРУУЛГА: Уншигчдын бичсэн сэтгэгдэлд MNB.mn хариуцлага хүлээхгүй болно. ТА сэтгэгдэл бичихдээ хууль зүйн болон ёс суртахууны хэм хэмжээг хүндэтгэнэ үү. Хэм хэмжээг зөрчсөн сэтгэгдэлийг админ устгах эрхтэй. Сэтгэгдэлтэй холбоотой санал гомдолыг 70127055 утсаар хүлээн авна.